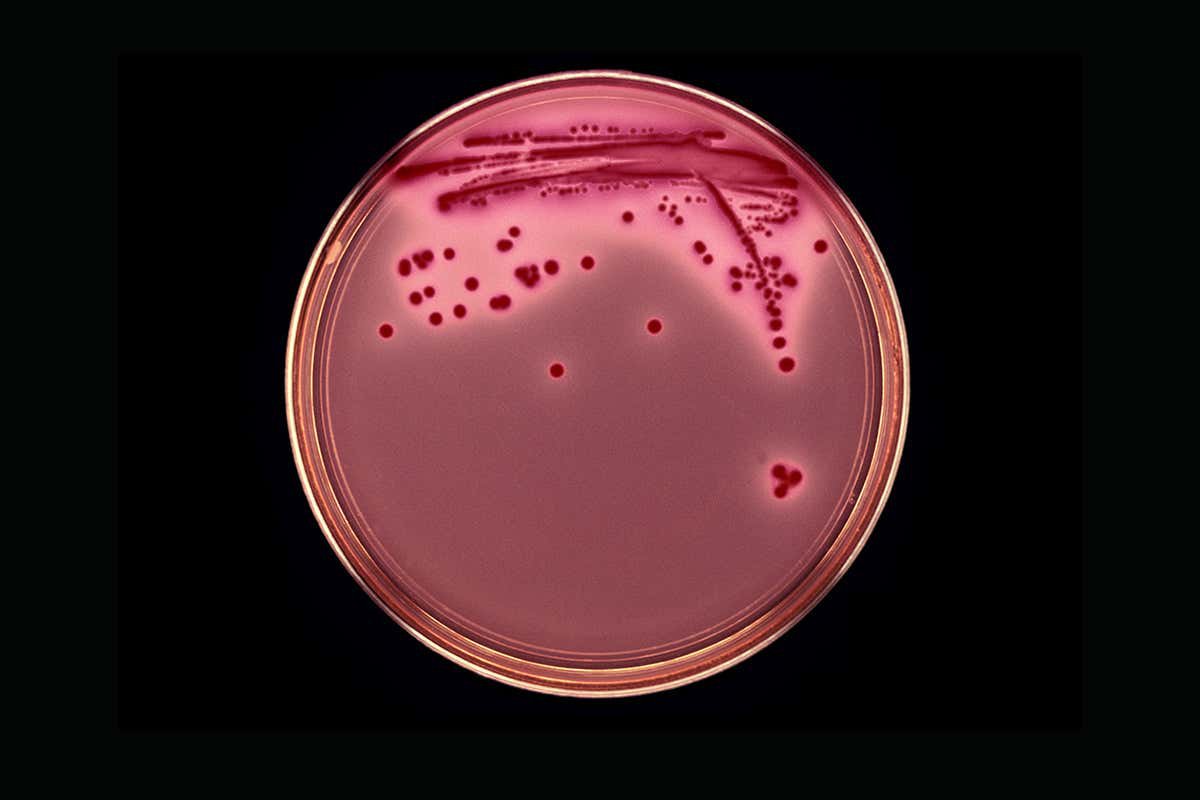
cấy vi khuẩn

1. Mục tiêu điều trị
1.1 Thuốc kháng acid
1.2 Thuốc chống bài tiết acid
- Các thuốc ức chế thụ cảm H2 ở điểm cảm thụ trên tế bào thành làm cho Histamin H2 mất tác dụng
- Biệt dược: Cimetidine, Ranitidine, Famotidine,...

1.3 Bảo vệ niêm mạc (tăng cường yếu tố bảo vệ): Sucralfat, Bismuth1.4 Thuốc ức chế bơm Proton
- Cơ chế: làm mất hoạt tính của men H+/K+ ATPase (bơm Proton)
- Biệt dược: Omeprazole, Lansoprazole
- Pantoprazole, Esomeprazole, Rabeprazole
2. Chỉ định điều trị nhiễm H.pylori ở trẻ em
Xác định có H. pylori dương tính bằng các Xét nghiệm đáng tin cậy trên trẻ:
- Có các triệu chứng tiêu hóa và có tổn thương trên nội soi/mô bệnh học
- Thiếu máu thiếu Sắt không tìm thấy nguyên nhân
- Xuất huyết Giảm tiểu cầu tự miễn không tìm thấy nguyên nhân
- Lựa chọn đầu tiên để điều trị nhiễm H.pylori là phác đồ kết hợp 3 thuốc trong đó gồm 2 kháng sinh và PPI, sử dụng 2 lần/ngày
- Thời gian điều trị 14 ngày
- Cấy vi khuẩn và kháng sinh đồ nên được làm nhất là ở các cộng đồng có tỷ lệ kháng kháng sinh cao, và các trường hợp điều trị thất bại
Khi các em bé đã được chẩn đoán xác định Viêm dạ dày thì nên đến các bác sĩ chuyên khoa để được điều trị theo đúng phác đồ.






